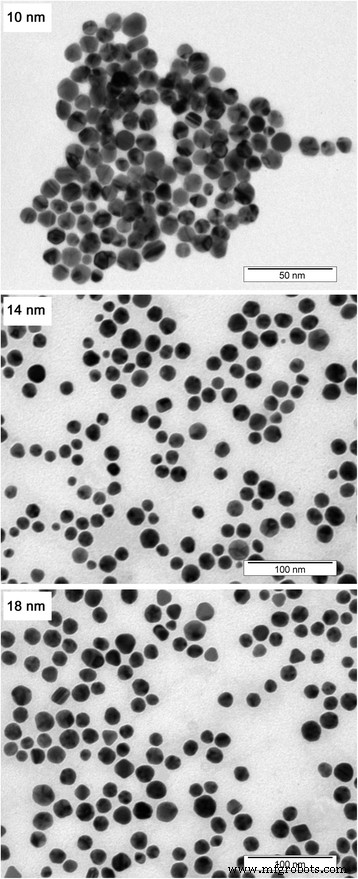
Impact of Gold Nanoparticle Size and Concentration on Root Development in Arabidopsis thaliana

Impact of Gold Nanoparticle Size and Concentration on Root Development in Arabidopsis thaliana
Abstract
Gold nanoparticles (AuNPs) are increasingly employed across industrial sectors, raising concerns about their environmental persistence and biological effects. Here, we report the synthesis of monodisperse, spherical AuNPs ranging from 10 to 18 nm, characterized by AAS, ICP‑MS, DLS, and TEM. We examined how particle size and concentration (1, 10, and 100 mg L-1) influence the primary and lateral root growth of Arabidopsis thaliana. The round morphology and absence of agglomeration ensured that DLS and TEM size distributions matched closely. All AuNP sizes reduced lateral root length and number at high concentrations, while the smallest particles (10 nm) inhibited primary root elongation but promoted root hair development. These findings highlight the size‑dependent phytotoxicity of AuNPs and underscore the need for careful environmental management of noble metal waste.
Background
Modern chemistry generates vast quantities of nanostructured materials—including nanoparticles, nanorods, and nanotubes—to enhance product performance in cosmetics, healthcare, bioengineering, energy conversion, and catalysis [1–10]. As these engineered nanomaterials reach the end of their useful life, they can release stable noble metal nanoparticles (e.g., Au, Ag, Pt, Pd) that persist in soils for years, potentially interacting with plant systems in unknown ways. Early work on silver nanoparticles (AgNPs) demonstrated that concentrations below 1 ppm can inhibit the growth of Arabidopsis thaliana seedlings, with effects strongly dependent on particle size and dose [11–13]. In contrast, research on gold nanoparticles (AuNPs) remains sparse, with most studies focusing on mammalian cytotoxicity [14–20] rather than plant responses. This gap limits our understanding of how AuNPs are taken up, transported, and accumulated within the food chain.
In this study, we systematically evaluate how AuNPs of distinct sizes affect the development of primary and lateral roots in A. thaliana. We synthesize citrate‑stabilized AuNPs with controlled diameters, thoroughly characterize them, and expose seedlings to a range of concentrations while monitoring root architecture.
Experimental
Materials, apparatus, and procedures
AuNPs were produced by a modified version of the citrate reduction method described by Batús et al. [20] Briefly, 149 mL of Milli‑Q water (18.2 MΩ cm) was refluxed in a 250 mL two‑necked flask. One milliliter of 0.33 M sodium citrate and 0.945 mL of 10 mg mL-1 potassium tetrachloroaurate(III) were then added. After 30 min of stirring, the mixture was cooled to room temperature. The resulting colloids contained 10, 14, and 18 nm AuNPs in separate batches.
For plant assays, AuNPs were centrifuged at 5,000 g for 1 h to concentrate them to 2,000 mg L-1. A. thaliana Columbia (Col‑0) seeds were surface‑sterilized in 30 % (v/v) bleach for 10 min, rinsed five times with sterile water, and sown on ½ MS agar (1 % agar, pH 5.8). Seedlings were synchronized at 4 °C for 2 days, then grown vertically for 5 days at 22 °C under a 16 h light/8 h dark cycle (100 µmol m-2s-1).
Five‑day‑old seedlings were transferred to 1/16 MS plates containing 0, 1, 10, or 100 mg L-1 AuNPs. AuNPs were added post‑autoclaving to avoid aggregation. Root lengths were recorded after an additional 5 days using JMicroVision 1.2.7 software.
Analytical methods
AuNP concentrations were quantified by atomic absorption spectroscopy (AAS) at 242.8 nm (Varian AA880). ICP‑MS (Agilent 8800) measured residual Au3+ ions. Dynamic light scattering (DLS) was performed on a Malvern Zetasizer ZS90, and transmission electron microscopy (TEM) images were obtained on a JEOL JEM‑1010 at 400 kV. All methods ensured <3 % analytical uncertainty.
Results and discussion
Nanoparticle characterization
Table 1 summarizes the size, distribution, and concentration data for each AuNP batch. TEM revealed narrow size distributions (± 2 nm) and perfect spherical morphology, while DLS confirmed the absence of significant aggregation. ICP‑MS showed that centrifugation reduced residual Au3+ ions by two orders of magnitude, ensuring that observed biological effects were attributable to intact nanoparticles.

Number‑weighted DLS size distributions for 10, 14, and 18 nm AuNPs. Insets display raw intensity data. Sizes are reported in nm.
TEM micrographs of the 10, 14, and 18 nm AuNPs, illustrating consistent spherical shape across sizes.
Adapting nanoparticle solutions for plant assays
AuNPs readily aggregate in full MS medium, altering their optical properties. We therefore diluted the 1/16 MS medium to minimize ionic strength while preserving plant growth conditions. This adjustment reduced visible color changes and maintained colloidal stability. Autoclaving at 121 °C caused irreversible aggregation, so we added AuNPs to agar that had been heat‑sterilized at 60 °C instead.
Effect on root growth
All AuNP sizes significantly reduced the length and number of lateral roots (LRs) at the highest concentration (100 mg L-1), with reductions up to 50 % in length and 30 % in number (Fig. 3). Primary root elongation was most affected by the 10 nm particles, showing a dose‑dependent inhibition at 100 mg L-1. In contrast, the 14 and 18 nm particles had negligible effects on primary roots, comparable to the citrate buffer control.

Impact of AuNPs on (a) lateral root length, (b) lateral root number, and (c) primary root elongation. Data represent mean ± SD (n = 19–20). Statistical significance: * p < 0.05, ** p < 0.01, *** p < 0.001.
Notably, 10 nm AuNPs promoted root hair proliferation in a concentration‑dependent manner (Fig. 4). At 100 mg L-1, root hair density increased markedly, a response often linked to phosphate deficiency but here driven by nanoparticle exposure. Larger AuNPs did not elicit this effect.

Root hair response to 10 nm AuNPs: (a) control; (b) 1 mg L-1; (c) 10 mg L-1; (d) 100 mg L-1; (e) close‑up of hair induction at 100 mg L-1 (scale bars = 1 cm).
Conclusions
We have demonstrated that carefully synthesized, monodisperse AuNPs can be maintained at biologically relevant concentrations without significant aggregation. Size and dose critically influence root architecture in A. thaliana: smaller particles (10 nm) impair primary root elongation and stimulate root hair growth, whereas all sizes reduce lateral root development at high concentrations. These results highlight the phytotoxic potential of AuNPs and emphasize the importance of responsible waste management for noble metal nanomaterials.
Abbreviations
- AAS:
Atomic absorption spectroscopy
- AgNPs:
Silver nanoparticles
- AuNPs:
Gold nanoparticles
- DLS:
Dynamic light scattering
- ICP-MS:
Mass spectroscopy‑equipped inductively coupled plasma
- LRs:
Lateral roots
- MS:
Murashige and Skoog medium
- NMNPs:
Noble metal nanoparticles
- NPs:
Nanoparticles
- TEM:
Transmission electron microscopy
Nanomaterials
- Gold Nanoparticles: Advancing Diagnostic and Therapeutic Applications in Medicine – A Comprehensive Review
- Amphiphilic Hyperbranched Polyglycerol Enables Size‑Controlled, Stable Gold Nanoparticles for Hydrocarbon‑Based Nanofluids
- How Synthesis Route Shapes the Structure, Magnetism, and Hyperthermia Performance of La₁₋ₓSrₓMnO₃ Nanoparticles
- Gold Nanoparticle–Modified 6‑Mercaptopurine and Rabies‑Derived Peptide Enhance SH‑SY5Y Neural Cell Proliferation and Neurite Outgrowth
- Green Synthesis of Metal‑Oxide Nanoparticles with Gum Karaya and Their Ecotoxicological Impact on *Chlamydomonas reinhardtii*
- Zinc Oxide Nanoparticles: Antimicrobial Properties, Mechanisms, and Applications
- Ligand‑Free Iridium Nanoparticles: A Simple Aqueous Synthesis and Demonstrated In‑Vitro Biocompatibility
- Rapid One‑Pot Synthesis of Monodisperse CoFe₂O₄@Ag Core–Shell Nanoparticles with Exceptional Plasmonic and Magnetic Properties
- Enhanced Gene Delivery Using Gold Nanoparticles Functionalized with Chitosan, N‑Acylated Chitosan, and Chitosan Oligosaccharide
- Size-Dependent Photoelectrical Behavior of Individual Silicon Nanowires



